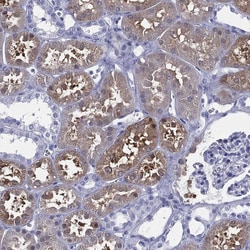
Invitrogen TMEM252 Polyclonal Antibody 100 &mu;L; Unconjugated:Antibodies,

Learn More
Invitrogen™ TMEM252 Polyclonal Antibody


Rabbit Polyclonal Antibody
Brand: Invitrogen™ PA5140356
Description
Gently mix before use. Optimal concentrations and conditions for each application should be determined by the user. Immunogen sequence: SNYRQVTESK GVLRHMLRQH LAHGALPVAT VDRPDFYPPA YEESLEVEKQ SCPAE Highest antigen sequence indentity to the following orthologs: Rat - 65%, Mouse - 69%.
Chromosome 9 consists of about 145 million bases and 4% of the human genome and encodes nearly 900 genes. Considered to play a role in gender determination, deletion of the distal portion of 9p can lead to development of male to female sex reversal, the phenotype of a female with a male X,Y genotype. Hereditary hemorrhagic telangiectasia, which is characterized by harmful vascular defects, is associated with the chromosome 9 gene encoding endoglin protein, ENG. Familial dysautonomia is also associated with chromosome 9 though through the gene IKBKAP. Notably, chromosome 9 encompasses the largest interferon family gene cluster. Chromosome 9 is partnered with chromosome 22 in the translocation leading to the aberrant production of BCR-ABL fusion protein often found in leukemias. The C9orf71 gene product has been provisionally designated C9orf71 pending further characterization.
Specifications
| TMEM252 | |
| Polyclonal | |
| Unconjugated | |
| TMEM252 | |
| C9orf71; E030010A14Rik; RGD1359349; TMEM252; Transmembrane protein 252; transmembrane protein C9orf71; transmembrane protein C9orf71 homolog | |
| Rabbit | |
| Antigen affinity chromatography | |
| RUO | |
| 169693 | |
| Store at 4°C short term. For long term storage, store at -20°C, avoiding freeze/thaw cycles. | |
| Liquid |
| Immunohistochemistry (Paraffin) | |
| 0.2 mg/mL | |
| PBS with 40% glycerol and 0.02% sodium azide; pH 7.2 | |
| Q8N6L7 | |
| TMEM252 | |
| Recombinant protein corresponding to Human TMEM252. Recombinant protein control fragment (Product #RP-99944). | |
| 100 μL | |
| Primary | |
| Human | |
| Antibody | |
| IgG |
Your input is important to us. Please complete this form to provide feedback related to the content on this product.